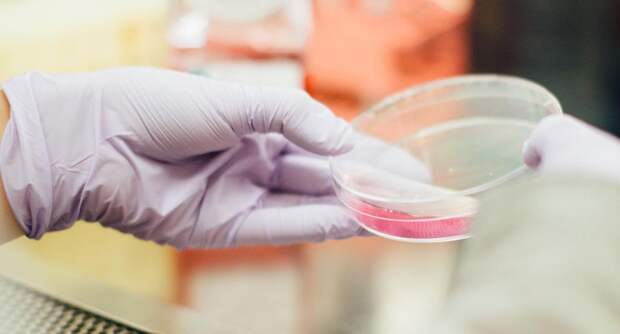

Министерство обороны раскрыло обман США, утверждавших, что их биолаборатории на Украине якобы деактивировали еще до начала спецоперации. Полученные оборонным ведомством документы опровергают эти заявления.
На информационном ресурсе применяются рекомендательные технологии (информационные технологии предоставления информации на основе сбора, систематизации и анализа сведений, относящихся к предпочтениям пользователей сети "Интернет", находящихся на территории Российской Федерации)
Министерство обороны раскрыло обман США, утверждавших, что их биолаборатории на Украине якобы деактивировали еще до начала спецоперации. Полученные оборонным ведомством документы опровергают эти заявления.
Понравилась статья? Подпишитесь на канал, чтобы быть в курсе самых интересных материалов
Подписаться
Свежие комментарии